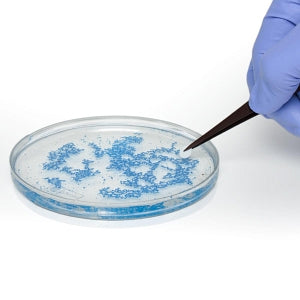
Bel-Art Sterile Cloning Disc - Sterile Cloning Discs, 1/8" Dia., Paper, Pack of 100 - F37847-0001

Bel-Art Sterile Cloning Disc - Sterile Cloning Discs, 1/8" Dia., Paper, Pack of 100 - F37847-0001
Out of stock
Sold out
$88.99
SKU F37847-0001
Discount Code: Use code TAKE5 for 5% OFF Total Purchase
Free Shipping Orders Over $100
Questions? Speak with a specialist!
 Chat with us!
Chat with us!
 Give us a call!
Give us a call!
 Email us!
Email us!
This item may require 5-7 days to ship out from our facility.
Product Information: Sterile Cloning Discs, 1/8" Dia., Paper, Pack of 100
Manufacturer Part # F37847-0001
Description
- Saves time and reduces effort when isolating a large number of clones
- Sterile paper discs transfer cells quickly and easily to 24-well plate
- Sterilized by gamma radiation
| HPIS Code | 80_60_30_0 |
| Latex Free | Yes |
| UNSPSC | 41116129 |